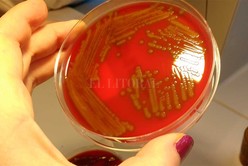

El Litoral / Rosario3.com

Explicación del doctor Gastón Chiganer sobre qué es el estreptococo del grupo A.

El Litoral / Rosario3.com
>> ¿Qué es el estreptococo del grupo A?
Los estreptococos del grupo A son bacterias que suelen estar presentes en la garganta y sobre la piel. La mayoría de las infecciones por estas bacterias producen enfermedades relativamente leves, como el estreptococo de garganta y el impétigo. Sin embargo, en ciertas ocasiones estas bacterias pueden provocar enfermedades mucho más graves y que pueden poner en peligro la vida, como la fascitis y el síndrome de shock tóxico estreptocócico.
Además, las personas pueden portar estreptococos del grupo A en la garganta o en la piel sin presentar síntoma alguno de la enfermedad.
>> ¿Cómo se contagian los estreptococos del grupo A?
Estas bacterias se contagian por contacto directo con secreciones nasales o de la garganta de personas infectadas con lesiones cutáneas infectadas. El riesgo de contagio es mayor cuando la persona se encuentra enferma, por ejemplo, cuando las personas tienen estreptococos en la garganta o en una herida infectada. Los portadores asintomáticos de la bacteria son mucho menos contagiosos. El tratamiento de una persona infectada con un antibiótico apropiado durante 24 horas o más, elimina la posibilidad de contagio con la bacteria. Sin embargo, es importante realizar el tratamiento completo con antibióticos tal como ha sido formulado. Artículos domésticos como platos, copas, juguetes, etc., no tienen mayor importancia en la transmisión de la enfermedad.
>> ¿Qué provoca?
Un 10-12% de niños sanos tiene la bacteria en las amígdalas, pero no les da problemas. Estos niños se llaman portadores y, salvo casos muy raros, no hay que tratarlos.
Cuando el estreptococo pyogenes invade la garganta provoca una faringoamigdalitis conocida como “anginas”. Esta es una de las infecciones más frecuentes en los niños. Esta bacteria es responsable de la gran mayoría de las faringoamigdalitis bacterianas en los niños. Es decir, que dos de cada tres casos de farignoamigdalitis en los niños van a ser producidas por virus, y no necesitarán antibiótico. Por eso, y antes de realizar el tratamiento, sería importante hacer una prueba diagnóstica que nos permita saber si esta bacteria es la responsable. Hoy en día existen tests rápidos de detección del Estreptococo. Con una pequeña muestra del exudado de la garganta de estos niños, en 3 a 7 minutos, podemos detectarlo. Si es positivo, la faringoamigdalitis está causada por la bacteria y entonces debemos darle antibiótico. En el resto de faringoamigdalitis no será preciso, de entrada, dar este tratamiento.
Si además de la infección de garganta, se produce una erupción en cuello, tronco y raíces de brazos y piernas estaremos ante la escarlatina. Está producida también por esta bacteria. Es bastante frecuente que esta enfermedad se dé en forma de brotes en centros escolares. Desde que existe tratamiento antibiótico, la escarlatina es una enfermedad leve con una rápida evolución a la curación sin secuelas.
Por último, esta misma bacteria puede dar muchas otras infecciones de diferente gravedad. Pero salvo las de piel (impétigo, erisipela, enfermedad perineal) y otras localizaciones en aparato respiratorio superior (otitis, sinusitis) son mucho más raras (neumonías, fascitis necrotizante, shock tóxico estreptocócico, meningitis).
>> ¿Es grave?
En la actualidad son infecciones consideradas como leves, salvo en raras ocasiones. Se sabe que si no tratamos la amigdalitis por Estreptococo, se resuelve espontáneamente en la mayoría de casos y en muy pocos días. El tratamiento antibiótico solo mejora en un día el malestar y la fiebre, pero es importante para evitar las complicaciones tipo fiebre reumática.
>> ¿Cómo prevenirlo?
El contagio de todos los tipos de infecciones estreptocócicas del grupo A puede disminuirse por medio del lavado de manos, especialmente después de toser o estornudar, antes de preparar comidas y después de comer. Quienes sufren dolor de garganta deberían consultar a un médico que pueda realizarles exámenes para determinar si tienen estreptococos de garganta. En caso afirmativo, la persona en cuestión no debe asistir al trabajo, al colegio o la guardería sino hasta después de 24 horas o más de haber tomado un antibiótico. Todas las heridas deben mantenerse limpias. Además, es necesario vigilar las heridas para detectar posibles síntomas de infección, entre los que se cuentan coloración roja en aumento, hinchazón y dolor en el lugar de la herida. Si estos síntomas se presentan, especialmente en personas que también presentan fiebre, consulte inmediatamente a un médico.
>> ¿Tienen tratamiento?
Sí. Se curan con antibiótico. Además, el Estreptococo pyogenes se trata sin problemas con los antibióticos de más uso, las penicilinas. No han aparecido cepas resistentes a ellas.
En la escarlatina y amigdalitis se recomiendan 10 días de tratamiento, algo más de lo habitual. Son pautas más efectivas para eliminarlo definitivamente de la garganta que las más cortas de 7-8 días.